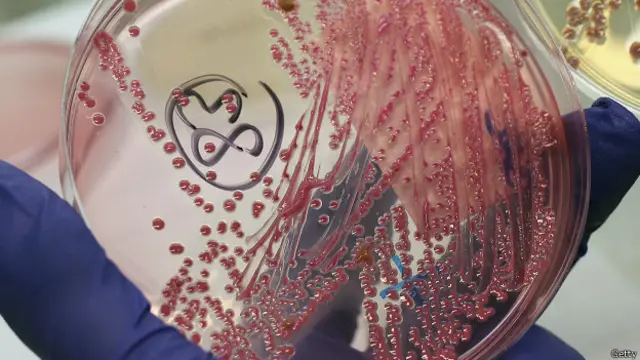
E.Coli

Los seres vivos que evolucionan jugando a "piedra, papel o tijera"

Fuente de la imagen, Getty
- Autor, Redacción
- Título del autor, BBC Mundo
La tijera corta al papel, el papel cubre a la piedra y la piedra rompe la tijera.
Las reglas las conoce casi todo el mundo y el juego se emplea –al menos en la infancia– para resolver innumerables disputas y dirimir competencias.
Y dos matemáticos de la Universidad de Cornell parecen haber confirmado que algunos importantes rompecabezas de la evolución también pueden explicarse a partir de las reglas y estrategias de "Piedra, papel o tijera", reportó recientemente la revista Science.
Un buen recordatorio de que variantes del popular juego también están presentes en la naturaleza.
Bacterias y lagartijas
Efectivamente, desde hace ya algunos años los científicos han encontrado que diferentes cepas de bacterias, que en principio no podrían convivir entre sí, pueden hacerlo en la práctica gracias a esta competencia "de a tres".
Fuente de la imagen, Getty
En su versión de "Piedra, papel o tijera" cada cepa se encarga de eliminar al enemigo de la otra, garantizando un equilibro dinámico que permite su coexistencia.
Este es, por ejemplo, el caso de la Escherichia coli, bacteria que produce y es a la vez sensible a las colicinas, un tipo de antibiótico de reducido espectro.
Las cepas de la E.coli que producen colicinas ("piedra"), matan a las cepas sensibles a las mismas ("tijera"), que a su vez son más fuertes que las cepas resistentes ("papel"), que por su parte son capaces de derrotar a las productoras ("piedra").
Y ahí está también el caso de algunas lagartijas, que compiten entre sí eligiendo entre tres estrategias diferentes –agresión, cooperación o engaño– para obtener pareja.

Fuente de la imagen, Getty
Como ocurre con el juego de "Piedra, papel o tijera", cada una de estas tácticas tiene garantizada la victoria frente a una de las alternativas y la derrota cuando se enfrenta a la otra.
Pero, en el caso de algunas lagartijas, los competidores no necesariamente mantienen una estrategia constante que en caso de éxito es perpetuada por las crías de los vencedores, como se asume en el modelo de las bacterias.
Y el trabajo matemático de Steven Strogatz y Danielle Toupo, del Centro para las Matemáticas Aplicadas de la Universidad de Cornell, ahora ofrece una explicación para ese comportamiento.
Buscando una ventaja
Strogatz y Toupo modificaron las ecuaciones que gobiernan las fluctuaciones de las estrategias en el tiempo para introducir la posibilidad de "mutantes".

Fuente de la imagen, THINKSTOCK
Es decir, jugadores que cambian de estrategia en pleno juego o de crías que no repiten la estrategia vencedora de sus progenitores.
Y encontraron que, en el largo plazo, esto termina provocando un patrón estable en el que cada una de las tres "armas" gana y pierde popularidad de forma cíclica y progresiva; un patrón que se repite incuso en especies que tienen niveles de mutación muy cercanos a cero.
"Nuestra principal conclusión es que el estado de coexistencia, en el que las tres especies existen en equilibrio, puede verse desestabilizada por tasas de mutación arbitrariamente pequeñas", afirman los matemáticos en su estudio "Dinámica no lineal del juego piedra-papel-tijeras con mutaciones", publicado en la edición de mayo de la revista Physical Review E.
Y, como explica Science, esto significa que un poco de mutación evita que el juego derive a una situación en la que todas las estrategias aparezcan en iguales números –lo que no le daría la ventaja a ninguna– o que sus proporciones fluctúen locamente.
Un hallazgo, afirma la revista, que ayuda a entender mejor las estrategias de competencia de los seres vivos en su lucha por la existencia.









